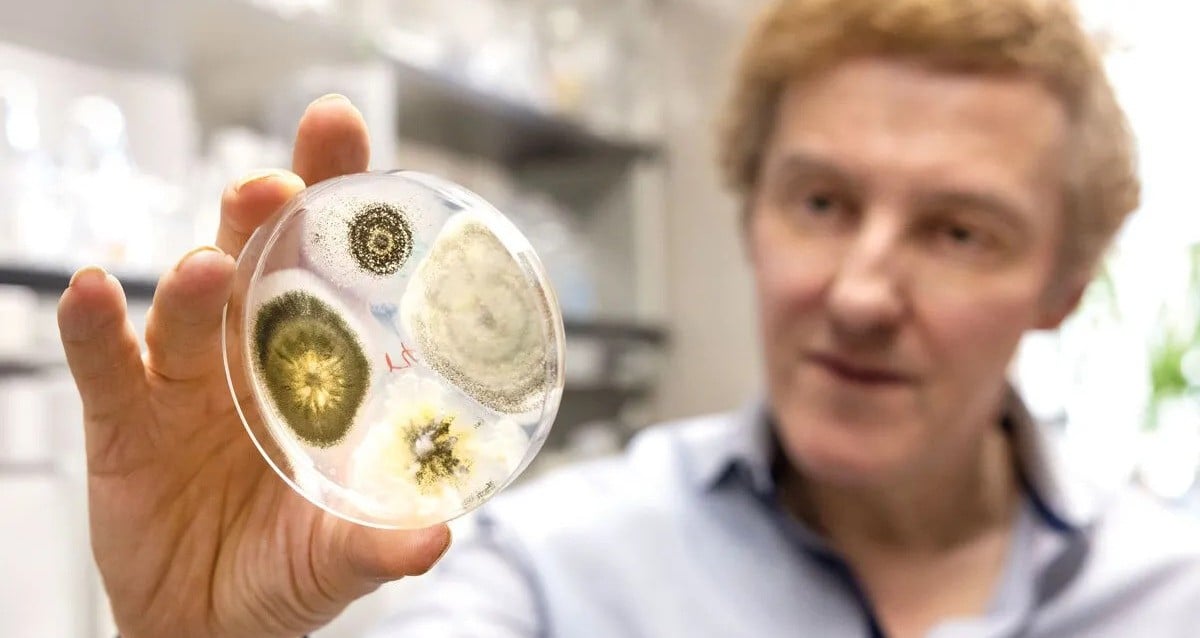
Genetically Modified Fungus Could Help Eradicate Mosquitoes

The genetically engineered Metarhizium fungus is just as attractive to mosquitoes as it is deadly.

University of MarylandThe study sought to take advantage of how mosquitoes are attracted to certain smells.
By some measures, mosquitoes are among the deadliest creatures on Earth. They carry diseases like malaria, and are notoriously difficult to eradicate. But a group of researchers has proposed a new solution to Earth’s mosquito problem: genetically modified fungi, which can successfully trap and kill mosquitoes.
By genetically engineering the Metarhizium fungus, which is already used to control bugs, the researchers may have invented a way to kill mosquitoes without extensive chemical intervention. Rather, this more “natural” way of eradicating mosquitoes may offer a new and more powerful solution to communities across the world.
How Researchers Used The Metarhizium Fungus To Attract And Kill Mosquitoes

University of MarylandStudy co-author Raymond St. Leger of the University of Maryland.
According to the researchers’ study published in Nature, the question of how to both trap and kill mosquitoes naturally began with a fungus called Metarhizium. Metarhizium is known to be deadly to mosquitoes, as the fungus can release fatal spores that kill the insects by overtaking their insides and consuming them. However, Metarhizium only emits longifolene — a compound with a “sweet” or “woodsy” smell that is highly attractive to mosquitoes — after it’s already killed an insect.
So the researchers set out to “turbocharge” the fungus.
“Mosquitoes need flowers because they provide nectar, a crucial source of food for them, and they are drawn to flowers through their scents,” study co-author Raymond St. Leger, a professor of entomology at the University of Maryland, explained in a university statement. “After observing that some types of fungi could trick mosquitoes into thinking they were flowers, we realized we could turbo-charge the attraction by engineering fungi to produce more longifolene, a sweet-smelling compound that’s already very common in nature.”
In order to turbocharge the fungus, the researchers created a genetically modified strain of Metarhizium that produces high levels of longifolene. Instead of producing the compound only when it killed insects, the researchers tweaked the fungus so that it produced longifolene on a consistent basis.
Then, they tested out their theory.

Mark Sherwood and Raymond St. LegerThe contraption used by researchers to test out their genetically modified fungus, which they found killed between 90 and 100 percent of mosquitoes that encountered it.
They found that once the fungus spores are placed in a trap, longifolene is quickly released. Mosquitoes are naturally drawn to the smell, but are overwhelmingly killed by the fungus itself. In fact, between 90 and 100 percent of mosquitoes who encountered the fungus in lab tests died within days, even when the Metarhizium traps were placed near humans and real flowers, other living things that also draw mosquitoes.
It made no difference if the trap was placed indoors or outdoors, and the fungus spores produce longifolene on such a consistent basis that the trap could be used effectively for months.
What’s more, researchers say that longifolene is not harmful to humans.
A Possible Way To Eradicate Mosquitoes “Naturally” Using Longifolene
The research into Metarhizium is especially revolutionary because it offers a more natural way to eradicate mosquitoes. Not only are other methods, including pesticides and fumigation, potentially harmful to people, but many mosquitoes have developed a defense against them. Metarhizium, however, promises a more effective and safer way to kill the bugs.
“The fungus is completely harmless to humans as longifolene is already commonly used in perfumes and has a long safety record,” St. Leger explained. “This makes it much safer than many chemical pesticides.”

Huiyu ShengA mosquito infected by two different species of Metarhizium fungi.
What’s more, it’s highly unlikely that mosquitoes will be able to develop a defense against the technique, since their very survival depends on the sweet smell found in flowers.
“If mosquitoes evolve to avoid longifolene, that could mean they’ll stop responding to flowers,” St. Leger stated. “But they need flowers as a food source to survive, so it would be very interesting to see how they could possibly avoid the fungus yet still be attracted to the flowers they need.”
Even if mosquitoes did learn to avoid longifolene, St. Leger continued, it would be possible for researchers to modify Metarhizium to produce different floral scents.
He also noted that research into killing mosquitoes is more important than ever, as rising temperatures around the world have created many ideal conditions for mosquitoes to thrive. Because they can carry dangerous diseases, it’s important for scientists to figure out a way to curb their populations. Metarhizium seems like a promising solution, but this doesn’t necessarily mean it’s time to put away the bug spray, as St. Leger and his fellow researchers are now looking into how Metarhizium might be used alongside other insect repellents.
“It’s not as if you’re going to necessarily find a silver bullet to control mosquitoes everywhere, but we’re trying to develop a very diverse and flexible set of tools that people in different parts of the world can use and choose from,” St. Leger said. “Different people will find different approaches work best for their particular situation and the particular mosquitoes they’re dealing with. In the end, our goal is to give people as many options as possible to save lives.”
After reading about the genetically modified fungus that traps and kills mosquitoes, discover the story of cordyceps, the “zombie fungus” from “The Last Of Us” that brutally kills insects by invading their bodies. Or, learn about the bullet ant, the insect with the world’s most painful sting.